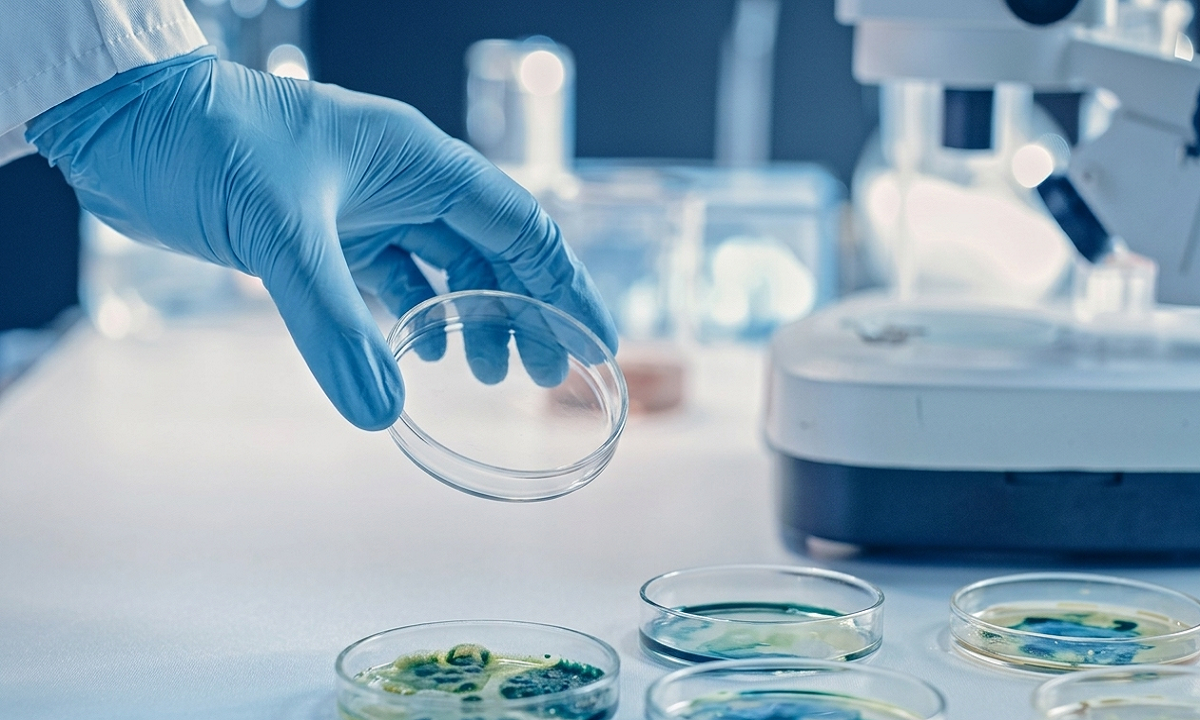

Un equipo de investigadores en China ha logrado un hito en la ciencia de materiales espaciales al medir, con una precisión sin precedentes, la conductividad térmica de una sola partícula de suelo lunar. El estudio revela que los aglutinados lunares poseen una capacidad de aislamiento térmico comparable a los aerogeles sintéticos más avanzados, estableciendo un nuevo récord para materiales naturales.
Hallazgos de la misión Chang’e-5
La investigación, difundida por Global Times (socio de TV BRICS), fue ejecutada por expertos de la Academia de Ciencias de China, la Universidad de Tsinghua y el Centro de Tecnología e Ingeniería para la Utilización del Espacio. Para el análisis, se utilizaron muestras recolectadas durante la histórica misión Chang’e-5.
Los resultados demuestran que ciertos componentes del regolito lunar presentan una conductividad térmica extremadamente baja en condiciones de vacío. Este fenómeno se debe a la compleja estructura interna de los aglutinados, la cual limita el transporte de fonones (vibraciones que transmiten calor), convirtiéndolos en aislantes ultradeficientes.
Leer también: Crean útero artificial: el primer paso hacia la gestación fuera del cuerpo
El suelo lunar
El suelo de la Luna es una mezcla heterogénea de fragmentos de roca, esferas de vidrio y aglutinados. Estos últimos han captado la atención de los científicos por su capacidad para resistir el entorno térmico extremo del satélite, donde las temperaturas fluctúan drásticamente.
Puntos clave del descubrimiento:
- Aislamiento récord: Es el valor más bajo de conductividad térmica jamás registrado en un material de origen natural.
- Estructura compleja: Las características porosas y fractales de las partículas dificultan el paso del calor.
- Simulación avanzada: El equipo utilizó técnicas de análisis estructural y simulación de última generación para validar los resultados.
Este avance no solo profundiza el conocimiento sobre la geología lunar, sino que abre la puerta a innovaciones tecnológicas tangibles:
- Exploración Espacial: El descubrimiento será fundamental para el diseño de naves espaciales, módulos de aterrizaje y futuras bases lunares, permitiendo una gestión térmica más eficiente ante el frío y calor extremos del espacio.
- Innovación en la Tierra: Los científicos sugieren que la estructura de estas partículas podría inspirar la creación de materiales aislantes de nueva generación para uso industrial y doméstico en nuestro planeta.
Con información de VTV

